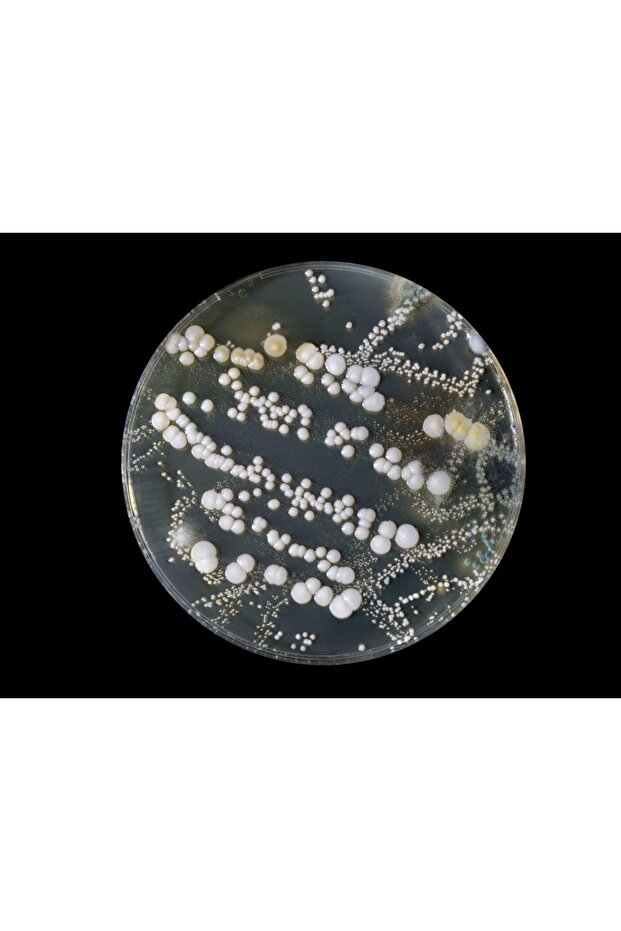
Bakteri Üretim Deney Seti - 1

Edulab Bakteri Üretim Deney Seti
651 TL
Öne Çıkan Özellikler:
Edulab Bakteri Üretim Deney Seti Özellikleri
Renk
Beyaz
Ürün Bilgileri

Edulab Bakteri Üretim Deney Seti Özellikleri
Renk
Beyaz
Güvenlik Bilgileri
Ürün Güvenliği Bilgileri
Yardım & Destek
Kategoriler
Kadın
Erkek
Anne & Çocuk
Ev & Yaşam
Süpermarket
Kozmetik
Ayakkabı & Çanta
Elektronik
Saat & Aksesuar
Spor&Outdoor
Flaş Ürünler
Çok Satanlar